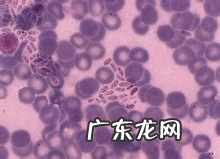
养宠物家中如何预防弓形虫病

文章插图
图4试验室确诊弓形虫病
二、弓形虫病的防止
现阶段对小宠物弓形虫病的医治都还没理想化药品 。临床医学常以用药治疗,针对弓形虫病有一定的实际效果 。因而,小宠物弓形虫病的防止就看起来至关重要 。大家根据下列对策能够降低小宠物感柒巨细胞病毒,也可降低人经小宠物感柒巨细胞病毒 。
1、留意喂养管理方法环境卫生,应当让猫固定不动住所,不必散养,任其在外面流荡;
2、给犬猫吃成品粮,不许其在外面随意觅食,以防吃完早已感柒巨细胞病毒的鼠或飞禽而把巨细胞病毒带回去;
3、每日消除犬猫排泄物,由于猫粪中的卵囊需要在外部生长发育二到五天才有传染性,因此 妥善处理猫粪十分关键;小宠物工作应与其他器材分离、按时为其清理入睡的软垫,不必让其躺在床上入睡;
4、防止被小宠物抓破、咬到,尽可能不必与小宠物太过亲近,如同学一起吃、同房共眠;尽可能不许小宠物舔每人必备及脸;常常给宠物洗澡 。

文章插图
图5猫弓形虫感柒
三、汇总与探讨
就现阶段的医药学水准来讲,小宠物弓形虫病的确诊与医治均存有一定水平可变性,因而要防止得小宠物弓形虫病,防止至关重要 。大家做为养宠物发烧友,要积极主动学习培训人畜共患病专业知识,提升防范意识,不可以盲目跟风的信心自己的小宠物身体状况,也不可以光凭猜想或是猜疑而生疏乃至丢弃自身抚养很多年的小宠物盆友 。
【养宠物家中如何预防弓形虫病】
特别声明:本站内容均来自网友提供或互联网,仅供参考,请勿用于商业和其他非法用途。如果侵犯了您的权益请与我们联系,我们将在24小时内删除。
